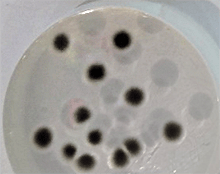

- コラム
食品中のカビの検査
2021年3月16日

私たちは日常生活でカビと深く関わっており、醤油や味噌、チーズ等の発酵食品を普段から食している一方、饅頭や餅、パン等の食品の変質や腐敗、浴室やシンク等の生活環境汚染、アレルギー等の問題に悩まされています。今回は、カビの概要と関連する検査を紹介します。
カビについて
カビは真核原生生物中の真菌類に該当し、真菌類はさらに簡易的に接合菌類、子嚢菌類、担子菌類および不完全菌類に分類されます。キノコは担子菌類、酵母は子嚢菌類が主に該当します。
一般に黒カビと呼ばれるクラドスポリウムは不完全菌類に該当し、空気中に浮遊するカビの中では最も多く、浴室等の湿気の多い場所や穀類、ケーキ、野菜等に繁殖します(写真1)。
アスペルギルス属は子嚢菌類に該当し、コウジカビとして醸造に使用されるものから発がん性のカビ毒を産生するものまで存在します(写真2)。
同類のアオカビはペニシリウム属で抗生物質のペニシリンを産生するもの、チーズの製造に使用されるもの、食品を汚染しカビ毒を産生するものが存在します(写真3)。
 |  |  |
| 写真1 クラドスポリウム | 写真2 アスペルギルス | 写真3 ペニシリウム |
カビに関連する検査
顕微鏡観察(異物検査)
上記のように、カビにはさまざまな種類が存在します。種類によって形態が異なるため、顕微鏡観察によって特徴を捉え、カビの主な属種を推定します。「検体に付着した白いものがカビかどうか」「どんな種類のカビが生えているのか」といった要望に対応します。通常3日で結果を出しますが、形態が見えない場合は培養時間をいただく場合があります。
カビ臭(臭気検査)
カビが発生する香気には、不快と思われるものからチーズやキノコなど身近な食品の風味を向上させるものまでさまざまです。臭気検査では、クレームを受けた試験品や品質管理として調べたい試験品に対してにおい成分を測定・分析し、そのにおいが何由来か(菌由来、他包材由来、食品由来等)を調べてご報告いたします。比較品との差をご報告することも可能です。
カビ同定
カビの持つD2 rDNA上の遺伝子配列を解析し、データベースと照合して種を推定する方法です。種によってカビ毒の産生や薬剤耐性、役割が知られているものがあるため、問題解決の手掛かりとして利用できます。
微生物検査
カビ数、酵母数、真菌数を測定します。検査方法としては、食品または汚染が懸念される試料について10倍希釈(もしくは段階希釈)し、CP加ポテトデキストロース寒天培地に塗抹します。至適温度である25℃で5~7日培養し、発生した集落数をカウントして、カビ数、酵母数および真菌数を算出します。
漬物の一部に酵母の基準が定められていますが、その他の食品には定められていません。酵母、カビが発見された場合に、異物や異臭クレームが発生する可能性があるため、主として品質確認のために微生物検査を行います。
カビ毒(有害物質)
カビ毒は、カビが有機物を分解して産生する物質のうち人体に影響を及ぼすものを指します。カビ毒の中には熱で分解されにくいものもあり、目に見えないため、食品にカビを発生させないよう管理することが大切です。
主な種類としては、落花生やナッツ類等に寄生するアスペルギルス属の一部が産生するアフラトキシン類、麦類等の穀類のフザリウム属が産生するデオキシニバレノールやゼアラレノン、りんご果汁を汚染するパツリン等があります。食品衛生法に基づいて基準値が定められているものもあり、確認しておく必要があります。
水分活性(成分)
水分活性(Aw)は微生物が利用可能な水分(自由水)の割合を表したもので、乾燥や砂糖/食塩の添加により水分活性を低下させ、微生物の増殖を抑えることができます。カビは水分活性が比較的低い値でも増殖可能な菌ですが、0.6以下では増殖できないため、干物やジャムなどの品質管理項目の一つとされています。
カビは高温多湿の場所に増殖しやすく、春から夏、秋にかけて増えることが予想されます。工場等の製造施設では温度上昇により冷蔵庫や冷凍庫に結露が発生し、一般家庭でも水回りは多湿になる可能性が高くなるため、早い段階からカビを増殖させない対策を講じることが重要です。

Mérieux NutriSciences Japanは、カビに関連する検査以外にも多数の検査を実施しております。
まずはお気軽にお問い合わせください。
参考文献
- かび検査マニュアルカラー図譜
- カビ対策マニュアル 基礎編-文部科学省
- 農林水産省が優先的にリスク管理を進めているかび毒(平成28年1月現在)
- 神奈川県衛生研究所 衛研ニュース No.148 食品とカビ


